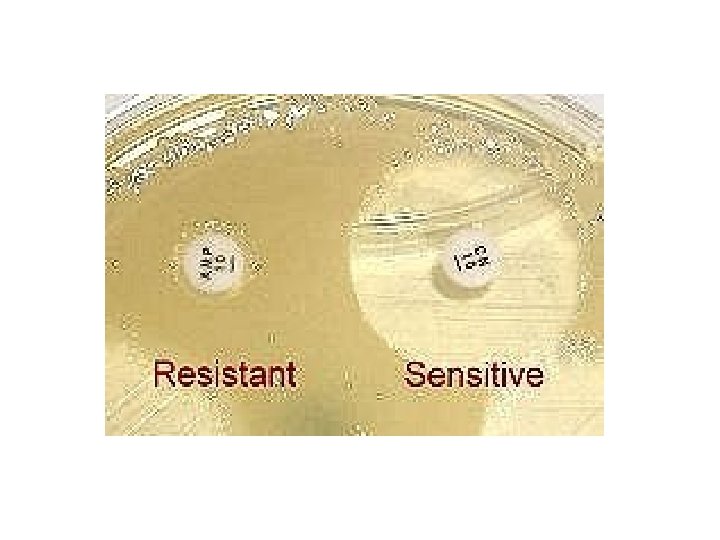

Isolamento e identificao dos Estafilococos Importncia Clnica dos

- Slides: 31
Isolamento e identificação dos Estafilococos
Importância Clínica dos Estafilococos Staphylococcus aureus Intoxicação alimentar (produção de enterotoxinas) Síndrome do choque tóxico Infecções hospitalares Osteomielite Endocardite Bacteremia MRSA (Staphylococcus aureus resistente à meticilina) VRSA (Staphylococcus aureus resistente à vancomicina) VISA (Staphylococcus aureus com resistencia intermediária à vancomicina) Staphylococcus epidermidis Staphylococcus saprophyticus
Abcessos
Síndrome da pele escaldada Toxina: Esfoliatina
Intoxicação alimentar
Síndrome do choque tóxico
Isolamento dos Estafilococos Staphylococcus saprophyticus Staphylococcus aureus Staphylococcus epidermidis
Identificação de Estafilococos 1) Prova da Catalase 2) Prova da Coagulase 3) Resistência à Novobiocina 4) Crescimento em ágar Manitol 5) Prova da DNAse
Prova da Catalase Conversão de peróxido de hidrogênio a 3% em água e oxigênio pela ação da catalase. 2 H 2 O 2 H 2 O + O 2 + Estafilococos Estreptococos OBS: Cuidado para não coletar ágar sangue junto com a colônia usada no teste falso positivo porque o sangue do agar contém catalase.
Prova da Catalase Staphylococcus spp Streptococcus spp
Prova da Coagulase Inocular colônia de bactéria em plasma de coelho incubar 37 ºC por 14 horas e observar formação de fibrina Fibrinogênio Fibrina + S. aureus - S. epidermidis S. saprophyticus
Prova da coagulase em tubo
Staphy test
Ágar Manitol (7, 5% Na. Cl) Manitol salgado Crescimento e fermentação (amarelo) S. aureus Sem Crescimento ou sem fermentação (rosa ou vermelho) S. epidermidis S. saprophyticus
Ágar Manitol (7, 5% Na. Cl)
Prova da DNAse Semear uma colônia em ágar DNAse e incubar a 35 graus por 24 horas. No momento da leitura adicionar HCl 1 N sobre a placa, aguardar 30 segundos e observar a formação de um halo claro ao redor da colônia. Ágar DNAse + S. aureus - S. epidermidis S. saprophyticus
PROVA DA DNAse
Prova de sensibilidade à Novobiocina Ágar Mueller-Hinton com disco de Novobiocina (5 microgramas) Sensível (-) S. aureus S. epidermidis Resistente (+) S. saprophyticus
Tabela para identificação de cocos Gram + Catalase + (Staphylococcus spp. ) Coagulase Manitol DNAse Novobiocina S. aureus + + + Sensível S. epidermidis - - - Sensível S. saprophyticus - - - Resistente Todos são Catalase +
Identificação de MRSA • • Teste de sensibilidade à oxacilina Teste de sensibilidade à cefoxitina PCR para o gene mec. A Detecção de PBP 2 a por aglutinação
Teste de sensibilidade à oxacilina e cefoxitina
PCR para mec. A
Aglutinação – Slidex (Biomerieux)